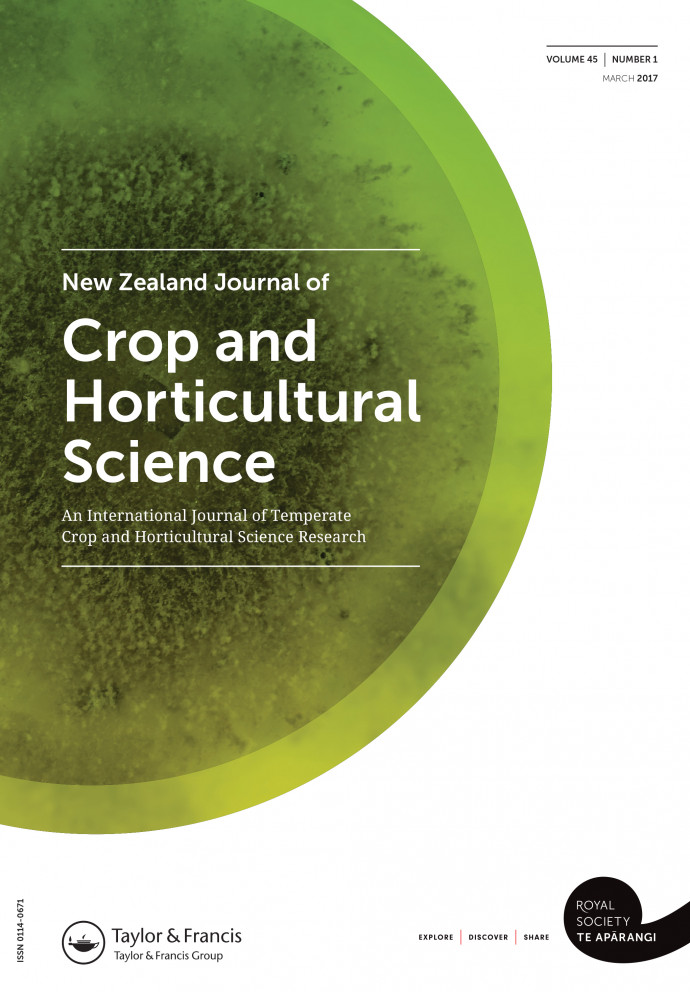

Current issue

Read the latest issue of the New Zealand Journal of Crop and Horticultural Science

Read the latest issue of the New Zealand Journal of Crop and Horticultural Science